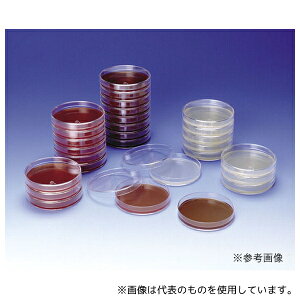

「卵」の人気商品一覧 | 安い商品を通販サイトから探す
820件 681〜720件を表示- 価格の安い順
- 価格の高い順
- 検索条件:
- 計測用具
- 本ページでは掲載するECサイトやメーカー等から購入実績などに基づいて手数料を受領しています。

温湿度計
Aeroor自動転卵機能があり、卵の均一な加熱を実現します。2時間ごとに自動で卵を回転。手作業不要で24時間安心、孵化の手間を大幅削減。内部モーターが静音設計で騒音を抑え、安定した動作で卵の位置を均一に調整します...

その他の計測用具
【自動卵反転機能】孵卵器は自動で卵を反転する機能に加え、反転回数カウントダウンタイマーと孵化日数を表示。均一な温度分布と安定した環境を維持し、孵化率を大幅に向上させます。 【温度・湿度表示】強力なファン駆動の空気循環シ
この商品で絞り込む

その他の計測用具
カモなどの鳥類の卵を自宅で孵化させることができる、学校研究用、家庭用、工場用の孵卵器です。 使用方法は簡単。ボタン操作と画面確認で孵化させる鳥を選択すると、自動的に温度を保ち、自動転卵を開始しま
この商品で絞り込む

温湿度計
ひと目でわかる。 カラー 本体サイズ-縦(cm) 本体サイズ-横(cm) 収納時サイズ 長さ 特徴●色の変化でお好みのゆで具合がよく見える。 用途 商品説明 付属品/セット内容 容量 入数 商品仕様 材質・素材ポリエステル樹脂 耐熱/...

その他の計測用具
●ふっ素加工により、こびりつきにくくお手入れが簡単。●コンパクトなデザインでコンパクトで収納しやすい。●賢いサイズでムダな電力・ガス代・スペースを省く「コンパクト」シリーズ●シングルライフやお弁当作り、狭いキッチンに
この商品で絞り込む

その他の計測用具
多様な卵収容サイズ:4個、7個、9個、12個、16個の卵を収容できるサイズで、様々な孵化ニーズに対応します。 インテリジェント温度制御:インテリジェント温度制御技術を採用し、温度を正確に調整して、胚の...

その他の計測用具
孵化場付属品 - 静音回転、風速、省エネと環境保護、排気ファン 全自動インキュベーター部品 - プラスチック素材で作られており、使いやすく、排気ファン 排気ファン - 純銅モーターを採用し、ファンがスムーズに動作し、騒音や強風を効果的...

温湿度計
温度、湿度、孵化経過日数などがリアルタイムでわかりやすく表示され、状況を確認しやすいです。 複数の卵を同時に入れて孵化させることが可能で、一度に複数の子鳥を孵化させることができます。 操作方法がシンプルで...

その他の計測用具
排気ファン - 底部の騒音を消音し、孵化を容易にします。孵化場の付属品 インキュベーター用排気ファン - 静音回転、風速、省エネ、環境保護、孵化場アクセサリー インキュベーターアクセサリー - 純銅モーターを採用し、ファンがスムーズに...

その他の計測用具
●合計入数:13●サイズ:φ9.5×19mm、φ12.5×25.4mm、φ16×31.8mm、φ16×38mm、φ19×41.4mm、φ19×50.4mm ×各2;φ19×76mm ×1●材質:アルニコV磁石(フッ素樹脂被覆)

温湿度計
お問い合わせください。TEL:045-243-0716 ■卵用温湿度データロガーEggTemp-RHの特長 ●卵の孵卵温度管理に特別に設計された温湿度
![電子スケールJQEJDKE家庭用ベーキンググラム精密小型食品小グラム (ミントグリーン,充電タイプ5 kg/0.1 g【充電ケーブル+トレイ+計量カップ+卵白セパレーター】) [並行輸入品]](https://m.media-amazon.com/images/I/312FLu+PfxL._SL500_.jpg)
はかり・天秤
多様なニーズに対応する高精度測定 コンパクトでポータブル、スペースを占有しません 操作が簡単で、老若男女に適している さまざまなユニットの切り替え、幅広い用途 耐久性のある材料、安定性と信頼性

その他の計測用具
【アズワン AS ONE】分析・特殊機器 動物・植物実験機器 飼育機器・用品 ●メダカ・タナゴ・フナ等小型魚類用の餌です。 ●高タンパク・高脂肪のハイカロリーな配合で、メスの親メダカがしっかり育ちます。 商品の仕様 ●組成:粗蛋白質51%
この商品で絞り込む

その他の計測用具
多様な卵収容サイズ:4個、7個、9個、12個、16個の卵を収容できるサイズで、様々な孵化ニーズに対応します。 インテリジェント温度制御:インテリジェント温度制御技術を採用し、温度を正確に調整して、胚の...

その他の計測用具
【アズワン AS ONE】分析・特殊機器 分離・分析ロシ 分析機器その他 ●黄色ブドウ球菌分離用 商品の仕様 ●生培地 ●内容量:10枚 ●JANコード:4987026159416 【※ご注意ください】商品は代表の画像を使用しています。
この商品で絞り込む
![[Yizibuur]小型インキュベーター 自動温度制御 ふ卵器 360°透明蓋で親子観察用 省エネ設計 1日1円以下 鶏 アヒル ウズラ インコ対応 自由研究 命の神秘体験](https://m.media-amazon.com/images/I/41UWyax9rUL._SL500_.jpg)
温湿度計
【自動精密温度制御】小型科教ふ卵器で、胚の発育に安定した環境を提供します。透明なカバーが360度パノラマ観察を可能にし、親子で卵の成長過程をはっきり見られます。インタラクションを通じて、家族の絆を深める教育的な体験ができます。 ...

墨つぼ・チョーク・マーカー
キャッチコピー卵殻から生まれたちょっとエコな粉チョークです。用途チョークライン用粉チョーク。特徴卵殻再利用100%で環境にやさしい粉チョークです。粉付がよく、鮮明なラインが引けます。たっぷり330g入りです。
この商品で絞り込む

その他の計測用具
●13?16.5cmx13?19cmの玉子焼にピッタリ●お手入れ簡単なふっ素含有シリコーン樹脂塗装●調理中に料理の様子がわかるガラス窓付●コンパクトサイズでムダな電力・ガス代・スペースを省く●シングルライフやお弁当作りに最適●賢いサイズで
この商品で絞り込む

その他の計測用具
特長 ●卵殻・炭カル兼用ライン引きです。 ●粉が安定して出やすいゴム羽根かくはん器構造です。 用途 ●グランド整備等に。 仕様 ●容量(kg):炭カル7.5 ●サイズ:幅23.5×奥行23.5×ハンドル高さ77cm(本体高さ43cm)...

その他の計測用具
●ふっ素加工により、こびりつきにくくお手入れが簡単。●コンパクトなデザインでコンパクトで収納しやすい。●賢いサイズでムダな電力・ガス代・スペースを省く「コンパクト」シリーズ●シングルライフやお弁当作り、狭いキッチンに
この商品で絞り込む
![■AS 【保存の際は要冷蔵】粉末培地テルル酸卵黄エマルジョン3785〔品番:6881403〕【4094169:0】[送料別途見積り][法人・事業所限定][外直送][店頭受取不可]](https://tshop.r10s.jp/hcvalor-eshop/cabinet/trusco/4094/trusco-4094169.jpg?fitin=300:300)
その他の計測用具
《メーカー》アズワン(株)《品番》6-8814-03《特長》《用途》《仕様》《仕様2》●粉末培地テルル酸卵黄エマルジョン3785《原産国(名称)》日本《材質/仕上》《セット内容/付属品》《注意》《JANコード》《本体質量》0.0g

その他の計測用具
均量ふ卵びんは±1%の精度で正確なサンプリングができます。硬質ガラス製。ガラスカラー共通摺り容量(mL):100栓共通:19*サイズ:全高:126mmつば上部までの高さ:110mm首付け根までの高さ:68mm胴径:54.2mm口内径:...

その他の計測用具
【カタログあり】【お見積もりOK】61-9628-05 ハンドぺたんチェックII 卵黄加マンニット食塩培地 PT4040 JANコード:4987026713403
この商品で絞り込む

墨つぼ・チョーク・マーカー
キャッチコピー卵殻から生まれたちょっとエコな粉チョークです。用途チョークライン用粉チョーク。特徴卵殻再利用100%で環境にやさしい粉チョークです。粉付がよく、鮮明なラインが引けます。たっぷり330g入りです。
この商品で絞り込む

測量用品
■卵用温度データロガー EggTempの特長 ●卵の温度管理用のデータロガーです ●実際の卵と同じように温度を検知測定できるようにデザインされています ●IP68適合で丸洗いが可能です ...

温湿度計
プローブ付きデジタル温度計:小型で軽量、持ち運びや保管が簡単、埋め込み型温度計 キッチン用温度計:プローブは防水で、お湯、塩水、屋外に置くことができます。温度計 キッチン用電子温度計:友人、家族、同僚への贈り物として使用できます。埋め...
その他の計測用具
【アズワン AS ONE】分析・特殊機器 分離・分析ロシ 分析機器その他 ●黄色ブドウ球菌分離用 商品の仕様 ●生培地 ●内容量:10枚 ●JANコード:4987026159416 【※ご注意ください】商品は代表の画像を使用しています。
この商品で絞り込む

その他の計測用具
【アズワン AS ONE】分析・特殊機器 分離・分析ロシ 分析機器その他 ●卵黄加マンニット食塩寒天培地は臨床材料、食品等から黄色ブドウ球菌の選択分離および生菌数の検査に用いられます 商品の仕様 ●生培地 ●用途:グラム陽性球菌用 ●入
この商品で絞り込む

その他の計測用具
全自動インキュベーター部品 - 均一な放熱、高温排気ファン、インキュベーターアクセサリー 排気ファン - 底部の騒音をミュートし、孵化を楽にする、インキュベーターアクセサリー インキュベーター用排気ファン - 静音回転、風速、省エネ、...

その他の計測用具
●ふっ素加工により、こびりつきにくくお手入れが簡単。●コンパクトなデザインでコンパクトで収納しやすい。●賢いサイズでムダな電力・ガス代・スペースを省く「コンパクト」シリーズ●シングルライフやお弁当作り、狭いキッチンに
この商品で絞り込む

拡大鏡・ルーペ
- 楽天市場
-
(157)
細かい作業 手相 夜間 暗い場所 職場 持ち運び 日常 祖父 祖母 両親 知人 ギフト 学習 観察 めがかの卵 水槽 地図 懐中電灯 防災 標本 地図 印刷物 電子機器 辞書
![電子スケールJQEJDKE家庭用ベーキンググラム精密小型食品小グラム (桜色,充電タイプ5 kg/0.1 g【充電ケーブル+トレイ+計量カップ+卵白セパレーター】) [並行輸入品]](https://m.media-amazon.com/images/I/31OuZx-xVAL._SL500_.jpg)
はかり・天秤
多様なニーズに対応する高精度測定 コンパクトでポータブル、スペースを占有しません 操作が簡単で、老若男女に適している さまざまなユニットの切り替え、幅広い用途 耐久性のある材料、安定性と信頼性

その他の計測用具
インキュベーションをサポートしながら、各重要な段階で胚の健康や発達を損なうことなく卵をクリアに観察できます。 用途が広い: 小さな卵にも大きな卵にも適しています。このエッグキャンドルは、適応性のあるデザインと信頼性の高いパフォーマンス...

その他の計測用具
多様な卵収容サイズ:4個、7個、9個、12個、16個の卵を収容できるサイズで、様々な孵化ニーズに対応します。 インテリジェント温度制御:インテリジェント温度制御技術を採用し、温度を正確に調整して、胚の...
![電子スケールJQEJDKE家庭用ベーキンググラム精密小型食品小グラム (ミントグリーン,バッテリータイプ10 kg/0.1 g【バッテリー+トレイ+計量カップ+卵白セパレーター】) [並行輸入品]](https://m.media-amazon.com/images/I/312FLu+PfxL._SL500_.jpg)
はかり・天秤
多様なニーズに対応する高精度測定 コンパクトでポータブル、スペースを占有しません 操作が簡単で、老若男女に適している さまざまなユニットの切り替え、幅広い用途 耐久性のある材料、安定性と信頼性
![電子スケールJQEJDKE家庭用ベーキンググラム精密小型食品小グラム (桜色,バッテリー5 kg/0.1 g【バッテリー+トレイ+計量カップ+卵白セパレーター】) [並行輸入品]](https://m.media-amazon.com/images/I/31OuZx-xVAL._SL500_.jpg)
はかり・天秤
多様なニーズに対応する高精度測定 コンパクトでポータブル、スペースを占有しません 操作が簡単で、老若男女に適している さまざまなユニットの切り替え、幅広い用途 耐久性のある材料、安定性と信頼性
![電子スケールJQEJDKE家庭用ベーキンググラム精密小型食品小グラム (アイボリーホワイト,充電タイプ10 kg/0.1 g【充電ケーブル+トレイ+計量カップ+卵白分離器】) [並行輸入品]](https://m.media-amazon.com/images/I/31adMtiHCNL._SL500_.jpg)
はかり・天秤
多様なニーズに対応する高精度測定 コンパクトでポータブル、スペースを占有しません 操作が簡単で、老若男女に適している さまざまなユニットの切り替え、幅広い用途 耐久性のある材料、安定性と信頼性
![電子スケールJQEJDKE家庭用ベーキンググラム精密小型食品小グラム (アイボリーホワイト,バッテリータイプ10 kg/0.1 g【バッテリー+トレイ+計量カップ+卵白セパレーター】) [並行輸入品]](https://m.media-amazon.com/images/I/31adMtiHCNL._SL500_.jpg)
はかり・天秤
多様なニーズに対応する高精度測定 コンパクトでポータブル、スペースを占有しません 操作が簡単で、老若男女に適している さまざまなユニットの切り替え、幅広い用途 耐久性のある材料、安定性と信頼性
計測用具カテゴリで検索されているキーワード:
お探しの商品はみつかりましたか?
検索条件の変更
ご利用前にお読み下さい
- ※ ご購入の前には必ずショップで最新情報をご確認下さい
- ※ 「掲載情報のご利用にあたって」を必ずご確認ください
- ※ 掲載している価格やスペック・付属品・画像など全ての情報は、万全の保証をいたしかねます。あらかじめご了承ください。
- ※ 各ショップの価格や在庫状況は常に変動しています。購入を検討する場合は、最新の情報を必ずご確認下さい。
- ※ ご購入の前には必ずショップのWebサイトで価格・利用規定等をご確認下さい。
- ※ 掲載しているスペック情報は万全な保証をいたしかねます。実際に購入を検討する場合は、必ず各メーカーへご確認ください。
- ※ ご購入の前にネット通販の注意点をご一読ください。
- ※ 本ページでは掲載するECサイトやメーカー等から購入実績などに基づいて手数料を受領しています。
- 卵
- DIY・工具
- 計測用具の通販情報・価格比較
- 価格.com
© Kakaku.com, Inc. All Rights Reserved. 無断転載禁止


